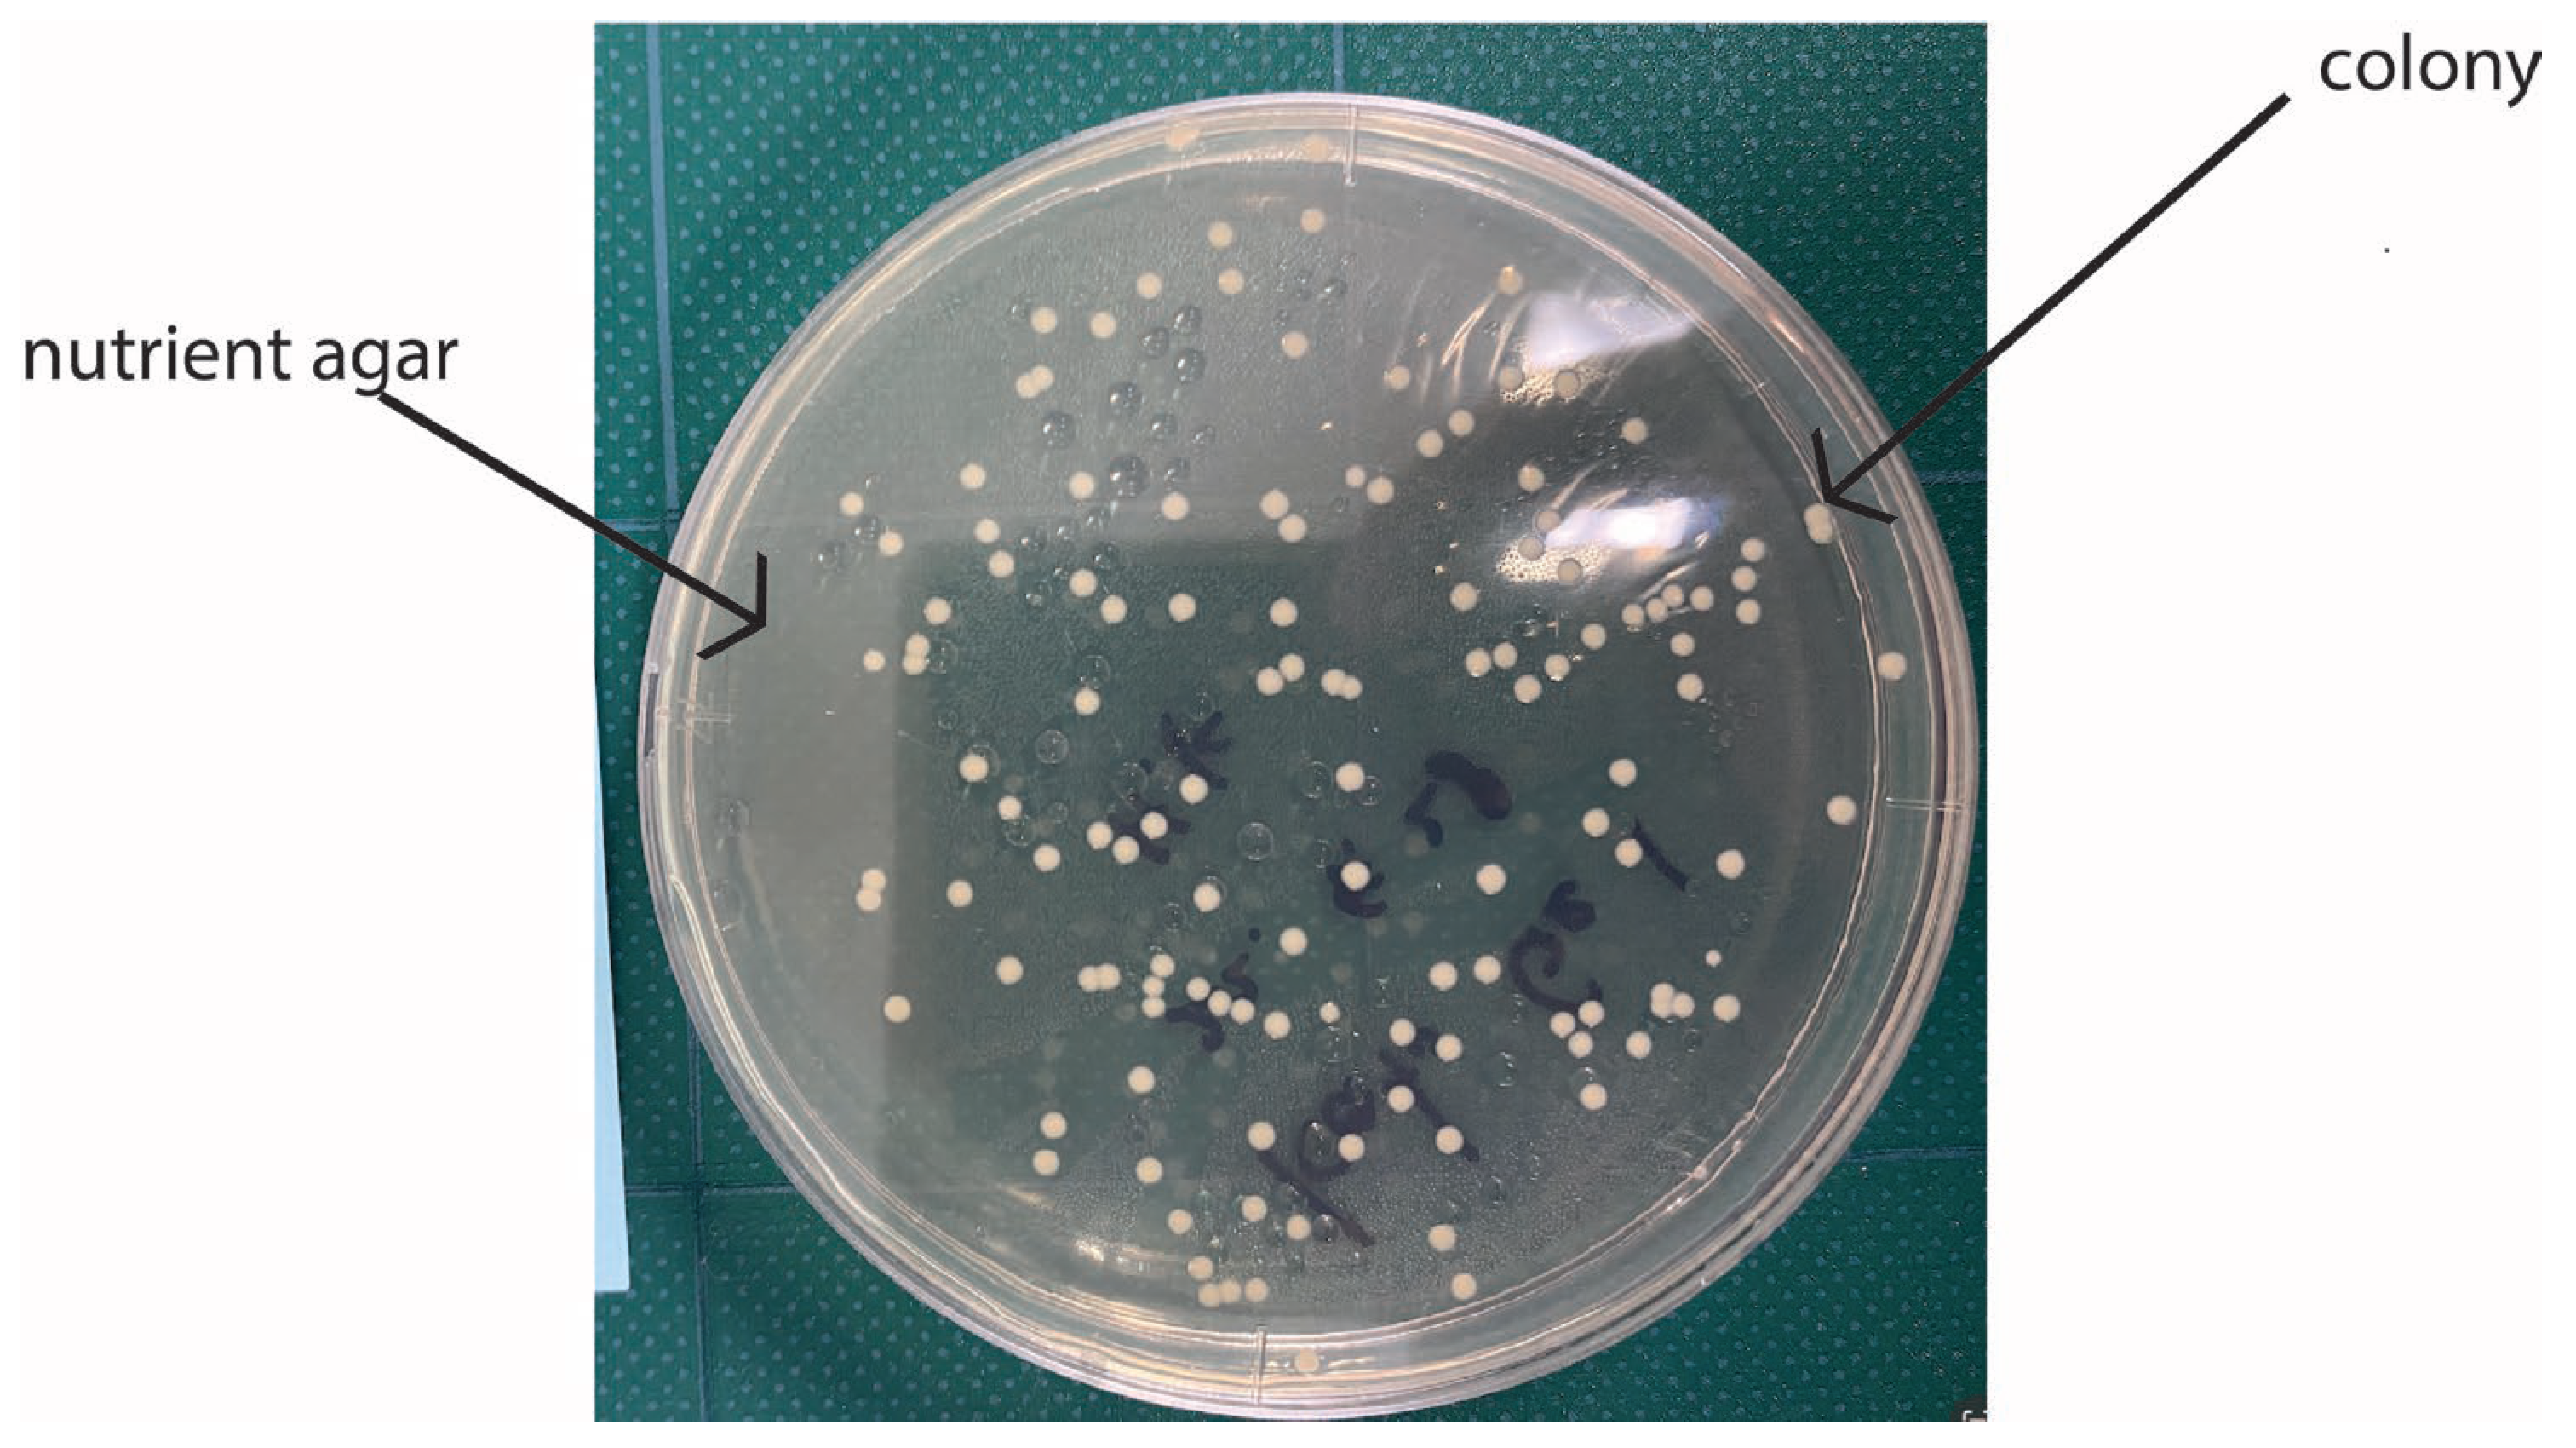
Preprints 103430 g002

1. Introduction
Since the COVID-19 pandemic began, people have become aware that materials (products) can transmit infection. They started to focus on questions such as the following. How can bacteria and germs, the sources of infection, maintain their infectivity on materials’ surfaces? To what extent can materials prevent this from happening [
1,
2]}? On the other hand, for the past 10 years, we have been discussing the standardization of direct evaluation methods for materials and products with SIAA (The Society of International Sustaining Growth for Antimicrobial Articles). This is a certification body mainly composed of Japanese companies [
3]. The number of member firms was almost 200 just before the COVID-19 epidemic. Now the number exceeds 1,200. The effort has already borne fruit as ISO 4768:2023 on July 18, 2023. (Measurement method of antibiofilm activity on plastic and other non-porous surfaces) [
4]. On the other hand, standards for antimicrobial products came to fruition in 2007 as ISO 22196 [
5] and for antiviral products as ISO 21702 in 2019 [
6], coincidentally just before the COVID-19 epidemic. The authors have studied the academic basis for the operation of the standards and were deeply involved as researchers in establishing one of the standards [
7]. We want to introduce these standards in this paper and critically compare them. Through the comparative study, we will be able to find some common principles regarding the correlative reactions of bacteria and viruses on the surface of materials and in the environment. The findings and discussion will lead to the development of new antibacterial, antiviral, and antibiofilm materials.
2. Antimicrobial Resistance Tests and the ISO Standard
Materials have long been known to resist bacteria [
8,
9,
10,
11,
12]. It is assumed that there was a scientific basis for the ancient use of bandages soaked in silver compounds, silver and copper tableware, and copper tubs. However, as science and technology have progressed, some reasons for this have become apparent, although theories still need to be settled.
Many attempts have been made to evaluate the antimicrobial properties of materials’ surfaces [
13,
14,
15,
16,
17,
18,
19,
20]. Only a few have been studied to the point of being standardized as a common method. The most famous is the film covering method. As written above, ISO22196 for evaluating antibacterial products was established in 2007.
Figure 1 shows the process schematically. This method, also known as the film covering method, is the only test method in the world for evaluating the antimicrobial resistance of materials.
The test organisms are pre-cultured in an appropriate culture medium. Then one dilutes it to a predetermined concentration and inoculates the surface of the specimen with a predetermined amount. Next, it is covered with a polymer film such as polypropylene film and incubated for a predetermined period. The petri dish is then incubated at 35°C with less than 90% humidity. It is inoculated on an agar medium in a fixed amount and incubated at 35°C for 24 hours. The colony formation units (CFU: Colony Formation Units) are counted.
Figure 2 shows a concrete example of colonies in agar powders.
Antimicrobial activity values, for A, are defined in this standard, as shown in Equation (1).
By convention, the standard specifies that an antimicrobial activity value of 2 or more, (i.e., a reduction in the number of viable bacteria to one-hundredth) is considered to indicate that the product had antimicrobial activity.
In the so-called film covering process, in which a bacterial solution is placed on a sample and covered with a PE film, a mutual reaction between the material and the bacterial solution is induced, and the results are reflected in the test results.
The above film adhesion method is the only standard worldwide for evaluating antimicrobial resistance as a material property. The key point of the film adhesion method is that the test specimen and the test bacterial liquid are adhered to each other by covering them with a film to ensure a reliable reaction. However, although non-reactive films (e.g., PE films) are used, their effects may not be absent in some cases. In addition, individual differences in the ability or inability to adhere to the foils may affect the results. To avoid this, the method does not use a film but evaluates by dropping a fixed number of droplets onto the material. As already mentioned, the advantage is simplifying the process by not using film and eliminating its effects. On the other hand, the inability to spread the bacterial solution uniformly causes variations in the contact area of the droplets, and the dispersal of the bacterial solution. Drying causes the death of the bacteria. Selecting an evaluation method by comprehensively considering these advantages and disadvantages is necessary. This method is called the “drop method”.
Both methods described above were designed for flat samples. However, the material to be evaluated is not always flat. One evaluation method developed for such cases is the “shake method” described below. This method was originally intended for textile products. The test solution is adjusted to 1.0-5.0x105 CFU/ml by placing 10 ml of 1/500 bouillon medium + bacterial solution in a polyethylene bag (70 mm x 100 mm). Then 30 ml of the bacterial solution, the sample, and air are sealed by heat sealing. The bag is then incubated at 35°C for 24 hours, and the viable bacterial count is measured.
This “shake method” was modified for plate specimens. In this test method, instead of the bag of the shake method, a sterilized polystyrene case with an inner surface composed of several cells is used. Each cell is filled with 5 ml of phosphate buffer and 1 ml of bacterial solution. Each cell contains 5 ml of phosphate buffer, 1 ml of bacterial solution (104 CFU/ml), and a test strip. It is incubated at 25°C for 1 hour to measure the number of viable bacteria. This method is called the “dip method”.
Apart from these, there is another method called the halo method. In this method, a circular or rectangular specimen is placed on an agar medium inoculated with a bacterial solution. It is incubated under certain conditions, and the antimicrobial activity is qualitatively evaluated by the size of the halo formed around the specimen.
3. Antiviral Resistance Test and Its ISO Standard
The concept of the film covering method, which was used to evaluate antimicrobial agent levels, is also used to assess antiviruses. At first glance, one will notice the similarity with the antimicrobial evaluation method. There are two significant differences.
First, the viral fluid interacts with the material, not the bacteria. The film adhesion method is used to cause a reaction between the material and the virus. In other words, a certain amount of virus solution is placed on the material’s surface, covered with a PE film, and allowed to lapse for a certain period. The virus used can be one that is problematic in a particular country. In Japan, canine influenza viruses (A/Hong Kong/8/68:TC adapted ATCC VR-1679) and feline calicivirus (F-9 ATCC VR-782), which has a structure like that of norovirus, are used to simulate influenza, which often causes epidemics during the winter season.
Another difference is that viral activity is evaluated by the degree of damage to animal cells by the virus, not by the colonies formed on agar. Viruses that react with the surface of the material by the film covering method should change their activity to a greater or lesser extent. If the activity does not decrease much, the virus will have a solid ability to destroy or transform cells. In contrast, if the activity reduces significantly, the virus is expected to hardly destroy or transform cells.
There are two ways to measure cell damage quantitatively. One is the TCID
50 assay [
21,
22,
23,
24,
25], which is used to measure morphological changes caused by viruses in cells. The TCID
50 assay is a conventional method of assessing viruses from a biological point of view, and it is shown schematically in
Figure 3. This method uses a phenomenon called “cytopathic effect: CPE” basically [
26,
27,
28,
29,
30]. Unlike bacteria, viruses are not capable of self-propagation [
31,
32,
33]. They invade a living cell called a host cell. They utilize the host’s growth process to multiply within the host cell, destroy the host cell, and then migrate out of the host cell to find another host and invade it. This process causes infection. Thus, when infection occurs, cells degenerate and are destroyed. Therefore, even though the virus is too small to observe, the effect of the virus (infection) can be confirmed by observing how the cells degenerate due to infection. This morphological change caused by the virus is CPE. The TCID
50 is a method for evaluating materials using such cellular degeneration.
Concretely speaking, the assay begins with preparing a series of dilutions of the virus and inoculating a certain amount of the virus solutions in cells filled with plastic wells after the film covering method. Then, they are incubated for a period, typically 24 -72 hours. After the incubation, the morphological change of cells is observed. The obtained results are calculated based on this method [
34,
35,
36]. The value of TCID
50 is the dilution at which 50% of the cell culture show CPE.
Another method is the plaque assay. In this method, the virus solution is inoculated into the cell culture medium and stained with a staining agent such as methylene blue. Areas that are infected with the virus and degenerated or detached are not stained by the staining agent. As a result, the portion of the cell infected with the virus is not stained. It forms an area that appears as a white circle. The number of these plaques is used as an evaluation criterion. This method has the advantage of being able to treat the invisible viral infection titer visually, as if it were the number of colonies seen in the case of bacterial growth. In the case of the TCID50 method, the evaluation of cellular degeneration (CPE) is often highly dependent on the skill of the assayer.
On the other hand, the plaque method seems less prone to errors and is more practical because the effect of infection can be confirmed numerically. The number of plaques is expressed as PFU (plaque formation unit), and as the number of a certain concentration. It is a number that reflects the infectivity.
Figure 4 shows a schematic process of a plaque measured by the author. In this case, the cells are MDCK cells, dog kidney cells, and the seeded virus is an influenza virus. Thus, PFUs can be counted as one would count colonies.
Let us consider the case where the number of plaques in the target specimen is Pi and the number of initial plaques in the non-processed specimen or control is P0.
In this case, the infectious titer of the virus can be defined by the following Equation (2).
These methods can be used to evaluate the infectivity (viral infection titer, titer) of viruses that are difficult to visualize at the nano-order.
4. Antibiofilm Resistance Test and Its Standard
Biofilm is a thin film of material that is formed when the number of bacteria adhering to the surface of a material increases and the bacterial density exceeds a predetermined value. At this point the bacteria simultaneously eject polysaccharides [
37,
38,
39,
40,
41,
42,
43,
44].
For both the antimicrobial and antiviral evaluations of the products, the film adhesion method was used as a method to cause interaction with the materials. The biofilm evaluation method differs from these methods in that it does not use the film adhesion method.
As already mentioned, biofilms are formed on the surface of materials by the action of bacteria.
Figure 5 shows the general process of biofilm formation. Bacteria floating individually in the environment (planktonic bacteria) are usually in motion in search of nutrients. Nutrients for many bacteria are carbon compounds, which are often adsorbed on the surface of materials. This is because material surfaces are energetically unstable (high state) and tend to be stabilized by the adsorption of various micromaterials. The micro-uniform film of carbon compounds is called a conditioning film. Bacteria adsorb on the material surface near the conditioning film to get nutrition. When the number of bacteria adhering to a surface exceeds a certain number (in a certain localized area) one of the signaling phenomena called quorum sensing occurs. It causes the bacteria to simultaneously produce polysaccharides.
A viscous, heterogeneous film-like substance is thus formed, in which the polysaccharides are mixed with the water on the surface of the material. This is a biofilm. The biofilm formed grows as a biofilm with a complex composition, containing inorganic and organic components from the substrate material, the environment, and dead bacteria. This biofilm will be strongly correlated with the substrate material. Their involvement depends on the cohesive strength of the base material, specifically, whether it is a metallic material, a ceramic, or a polymer. For example, in the case of metallic materials, ions are formed by dissolution. These ions interact with extracellular polymeric substances (EPS), which are biofilm components, The ions form complexes with them. In the case of polymers and ceramics, the interaction is different. Biofilms never continue to grow indefinitely. They will collapse at some point. Many factors may contribute to this. For example, a biofilm may leave the material under the influence of flow. Mechanical forces may also detach it. Other organisms may absorb the entire biofilm as nourishment. Even in the absence of these external factors, bacterial proliferation within the biofilm may progress, and the nutrition shared by the bacteria within the biofilm may become insufficient. This might lead to an imbalance between the number of bacteria and the amount of nutrition and result in the collapse of biofilm. From the destroyed biofilm, the bacteria revert to floating bacteria and float around, looking for other sites for biofilm formation. In this way, the biofilm is expected to gradually spread. As this example shows, antibiofilm properties are not the same as antibacterial properties. From an antibiofilm point of view, the most significant difference is that the major feature that forms biofilms is EPSs. Therefore, an appropriate biofilm evaluation method should include an evaluation of the EPS. It should also contain a quantitative evaluation method for its use and effect on industry.
Many methods for biofilm evaluation have been proposed. These methods range from those aimed at elucidating basic phenomena and proposing mechanisms to industrial evaluation methods.
Of course, biofilms are formed in the real environment. However, from the perspective of developing antibiofilm materials, it is sometimes difficult to conduct experiments in a real environment for various reasons. In such cases, accelerated tests that simulate the real environment are carried out in a laboratory. These methods for forming biofilms are called biofilm reactors. If the reactor is restricted to the laboratory, the reactor is referred to as a Laboratory Biofilm Reactor (LBR). LBRs can be broadly classified into two categories: static systems, in which materials are immersed in a bacterial fluid without considering flow, and flow systems, where the flow is considered [
44].
The colony biofilm assay is probably the easiest method for biofilm formation. Bacteria are inoculated onto an agar medium to form colonies. The bacterial-derived polymers aggregate and are observed [
45,
46,
47]. For this method, it seems to be difficult to distinguish biofilms with the naked eye. The combination of the material and bacteria forms biofilms. However, because the material side is an agar medium, it is impossible to see the effect of the combination of the material and bacteria. This is not sufficient (from the viewpoint of material development) because critical information is missing.
On the other hand, a microtiter plate assay has been proposed and implemented separately [
48,
49,
50,
51,
52]. This method uses plastic wells filled with a liquid medium, in which bacteria are inoculated. Biofilm is formed and the bacterial solution is removed. Then the vessel walls are stained with crystal violet solution to evaluate the amount of biofilm formation. Although this method was initially proposed for use in biology, it is like the Colony biofilm assay because it still needs the material combination. Using the biofilm assay, one can at least examine the behavior of biofilm formation on the plastic material since it is a plastic vessel wall. However, if the material is changed (for example, if one wants to measure biofilm formation behavior on metal), then it isn’t easy to evaluate the biofilm formation behavior. Therefore, one should immerse the target material in the wells, as in the experiment conducted by the authors [
2]. This concept has led to the international standard, which will be described later.
In contrast to these static methods, a reactor has been proposed that considers flow. Flow is very important in real-world conditions for biofilm formation. The details are described in Lewandowski’s work [
44] and the authors’ work [
1,
2].
The two main classifications for how the flow is created are as follows. One is a tubular system through which a liquid containing bacteria flows at a specific flow rate [
53,
54,
55,
56]. Biofilms form on the surface of the tube and are affected by the flow. Changes in flow velocity allow one to study the effects of shear stress on the biofilm. From the standpoint of materials research, the device’s shape, structure, etc., is determined by how the materials are secured inside the tube.
The other type is a reactor in which the flow is caused by rotation [
54,
56,
57,
58,
59,
60]. Various types of reactors have been proposed, depending on the rotation method. One can flow a bacterial solution to form a biofilm on a stationary material or place the material on a disk and rotate it. The point is that the rotation causes the total motion of the material and the bacterial fluid.
The above is a classification and brief description of laboratory biofilm reactors. On the other hand, it is necessary to analyze the properties of the biofilm formed by the biofilm reactor (qualitative analysis) and to measure its quantity (quantitative analysis). Various studies have been conducted on the evaluation of such analysis. Various methods have been proposed for analyzing biofilms. Biofilms on materials have been approached from the viewpoint of material surface analysis, using high-tech and often expensive analytical equipment.
The most successful method for evaluation is the use of confocal laser microscopy. A few examples are cited [
61,
62,
63,
64,
65]. Confocal Laser Scanning Microscopy (CLSM) provides optical tomography. This allows us to focus on a specific sample depth and obtain a clear image of that plane. Repeating this process allows each biofilm layer to be observed one after the other, and the three-dimensional structure can be reconstructed. The reason why biofilm observation with CLSM is so valuable is that this technology can visualize the three-dimensional structure of biofilms in high resolution and detail. Biofilms are aggregates of microorganisms. Therefore, detailed observation of their three-dimensional structure is essential to understanding their biological and physical properties. Many studies have analyzed biofilms using electron microscopy (SEM, TEM, and FIB-SEM) [
66,
67,
68,
69,
70,
71,
72,
73,
74], AFM or STM [
75,
76,
77,
78,
79,
80,
81,
82,
83,
84,
85,
86,
87,
88,
89,
90]. These studies provide excellent examples of topographically observing the shape of biofilms and the presence of bacteria. FTIR and Raman spectroscopy are complementary to each other, having their own strengths and weaknesses. It is most desirable to analyze them in combination.
The primary characteristic of biofilms is the presence of polymers derived from bacteria. Consider a mixture of polymers derived from bacteria, called EPS, which is the essence of biofilms. From a materials science perspective, they can be viewed as thin films of organic matter on various materials (products). Therefore, Raman spectroscopy, FTIR-ATR, is often used to measure biofilms because it is suitable for measuring organic matter formed on the surface of materials [
91,
92,
93,
94,
95,
96,
97,
98].
Analysis using these analyzers provides excellent qualitative findings. However, from an industrial standpoint, the quantitative nature of the analysis could be better.
As explained above, various methods have already been proposed and studied. However, none were inexpensive, quick, easy to use, or quantitative. In addition, as mentioned above, few evaluation methods attempted to quantify EPS. SIAA proposed a new quantitative evaluation method based on staining with crystal violet. This method was established as ISO4768:2023 on July 18, 2023. It is a measurement method of antibiofilm activity on plastic and other non-porous surfaces.
Biofilm evaluation should consist of two processes, as described above. They include the method of biofilm formation and its quantitative assessment. The biofilm production technique is displayed in
Figure 6. The bacteria used is Staphylococcus epidermidis (ATCC 35984). The bacteria are transferred to Tryptic soy broth (TSB) slope medium and incubated at 35°C for 48 hours. After incubation, one inoculates the inoculum into 1/5 TSB medium and incubates it at 35°C for 24 hours with shaking. Then the specimens are fabricated into 30 mm x 30 mm squares and attached to a 40 mm x 40 mm glass plate that was placed with the test surface facing up. Then it was placed in a sterilization container and steam-pressurized (121°C, 15 min) sterilized. Next, the specimens were placed in a sterilized cup. The pre-culture solution, which has been diluted to the third power of 10 CFU/ml and adjusted, is poured over the specimens so that they are at least 5 mm from the surface and incubated at 35°C for 48 hours. After incubation, the following steps are performed. Wash once with ion-exchanged water to remove the bacterial solution. Pour 0.1% crystal violet solution into a sterile cup, and stain for 30 minutes. Again, care should be taken to ensure that the crystal violet solution is at least 5 mm above the surface of the specimen. After 30 minutes, the surface is rinsed in the same manner. Wipe twice with a non-woven cloth, and dissolve in 5 ml of 1.0% sodium dodecyl sulfate solution. The sodium dodecyl sulfate extract is irradiated with light at 590 nm and the absorbance is measured.
Since absorbance cannot be an absolute value (physical property value), it may change each time. Therefore, if the absorbance of the target specimen obtained in the same test lot is I
0, the antibiofilm activity value R is defined by the following equation. For this equation, the absorbance of the control, I
c, and the antibiofilm activity of the target specimen are evaluated using this R.
The above test is based on N=3. Empirically, it is known that when the R value is 20% or more, the biofilm formation ability is so different that it can be seen by the naked eye. In other words, when the R value is less than 20%, there is almost no difference. When the R-value is negative, there is less antibiofilm effect than the control. However, comparisons between those with negative values are not usually made. See
Figure 7. Biofilm-related standards can be found in ASTM standards in the United States and EN standards in Europe. These two standards evaluate the antibiofilm properties of drugs, The standard promoted by the authors is the world’s first evaluation method for material properties.
4. Discussion
A discussion is provided about the work and results, along with information from previous studies and future research directions. The summary is as follows. All three standards are new in that they consider the interaction between materials and bacteria. The correlation with the material is achieved by artificial and accelerated interactions through film adhesion for antibacterial and antimicrobial applications. For the antibiofilm evaluation, natural contact is achieved by immersion, but acceleration is added by controlling the concentration and duration of time for bacteria to be in the environment. From a global perspective, most of the other standards are for drug testing, and this is an epoch-making standard because it evaluates the anti-infective properties of the material itself. Why do materials affect the activity of bacteria or viruses? Herein lies the basis of a common concept in the correlation between bacteria, viruses, and the biofilms they produce and the materials they use. When considering bacteria, viruses, and fungi in relation to a material, the direct correlation between these microorganisms or particles depends on the interaction forces between the material surface and the microorganisms or particles.
Figure 8 shows the concept of this hypothesis. In the case of metallic materials, the main force is the interaction between the metal ions formed on the material surface and the polymer component of the EPS or bacterial surface. In the case of polymers and ceramics, intermolecular forces between the material surface and the polymer components mentioned above are the main factors. For metallic materials, the main force is the interaction between the metal ions formed on the material surface and the polymer component of the EPS or bacterial surface. In the case of polymers and ceramics, intermolecular forces between the material surface and the polymer components mentioned above are the main factors. As for biofilms, an additional factor is the way a biofilm adheres to the material surface. In this sense, wettability such as the contact angle is another important factor.
The above hypotheses still need to be examined in detail. Although international standards have already been established for the test method, future work is needed to further clarify the interaction between the material and the biofilm and its mechanism. This will enable the development of new analytical methods, evaluation methods, and sensors.
5. Conclusions
This paper describes the standards for evaluating materials’ antibacterial, antiviral, and antibiofilm properties. It also includes an overview and the familiar concept of the interaction between materials and microorganisms. Establishing an everyday basis for evaluation methods will greatly help assure and improve quality in the industrial field. It will also provide a strong foundation for research and development. The standard needs further detailed academic support and refinement. Such a virtuous circle will lead to the further development of the discipline.
Author Contributions
Writing—original draft preparation, HK; Data curation, HM, AO, RKand TaK. Formal analysis, HK., HM., AO. and TaK, and TH.; project administration, H.K (Hideyuki Kanematsu)., H.M., H.N. and DMB; writing—review and editing, DMB.,ToK. And RI.; funding, HN. and HM.; investigation, TaK., AO., and HK.; Methodology, NH. and HM.; Project administration, HK., HM., ToK. RI and DMB.; supervision, ToK., and RI. All authors have read and agreed to the published version of the manuscript.
Funding
This work was supported by JSPS KAKENHI (Grants-in-Aid for Scientific Research from the Japan Society for the Promotion of Science, Grant Number 23K04465, 21K12739. A part of this work was supported by the GEAR 5.0 Project of the National Institute of Technology (KOSEN) in Japan.
Institutional Review Board Statement
Not applicable.
Informed Consent Statement
Not applicable.
Data Availability Statement
Not applicable.
Acknowledgments
We appreciate The Society of International Sustaining Growth for Antimicrobial Articles (SIAA) for their helpful advice and information about biofilms.
Conflicts of Interest
The authors declare no conflicts of interest The funders had no role in the design of the study; in the collection, analyses, or interpretation of data; in the writing of the manuscript; or in the decision to publish the results.
References
- Kanematsu, H.; Barry, D.M. Biofilm and Materials Science; Springer: New York, the USA, 2015; p. 196. [Google Scholar]
- Kanematsu, H.; Barry, D.M. Formation and Control of Biofilm in Various Environments; Springer Nature: Singapore, 2020. [Google Scholar]
- SIAA. SIAA home page. Available online: https://www.kohkin.net/en_index.html.
- International Standard Organization ISO 4768:2023 Measurement method of anti-biofilm activity on plastic and other non-porous surfaces. 2023, ISO 4768:2023, 1-12.
- International Standard Organization, ISO 22196:2011 Measurement of antibacterial activity on plastics and other non-porous surfaces. ISO/TC 61/SC 6 ICS: 83.080.01 2011, SO 22196:2011, 1-15.
- International Standard Organization, Measurement of antiviral activity on plastics and other non-porous surfaces. 2019, ISO 21702:2019, 1-20.
- Kanematsu, H.; Barry, D.M.; Ikegai, H.; Mizunoe, Y. Biofilm control on metallic materials in medical fields from the viewpoint of materials science–from the fundamental aspects to evaluation. International Materials Reviews 2022, 68, 247–271. [Google Scholar] [CrossRef]
- Vimbela, G.V.; Ngo, S.M.; Fraze, C.; Yang, L.; Stout, D.A. Antibacterial properties and toxicity from metallic nanomaterials. International journal of nanomedicine 2017, 12, 3941–3965. [Google Scholar] [CrossRef] [PubMed]
- Chen, S.; Popovich, J.; Zhang, W.; Ganser, C.; Haydel, S.E.; Seo, D.K. Superior ion release properties and antibacterial efficacy of nanostructured zeolites ion-exchanged with zinc, copper, and iron. RSC advances 2018, 8, 37949–37957. [Google Scholar] [CrossRef] [PubMed]
- Feng, A.; Cao, J.; Wei, J.; Chang, F.; Yang, Y.; Xiao, Z. Facile Synthesis of Silver Nanoparticle with High Antibacterial Activity. 2018.
- Nielsen, C.K.; Subbiahdoss, G.; Zeng, G.; Salmi, Z.; Kjems, J.; Mygind, T.; Snabe, T.; Meyer, R.L. Antibacterial isoeugenol coating on stainless steel and polyethylene surfaces prevents biofilm growth. J Appl Microbiol 2018, 124, 179–187. [Google Scholar] [CrossRef] [PubMed]
- Nielsen, C.K.; Subbiahdoss, G.; Zeng, G.; Salmi, Z.; Kjems, J.; Mygind, T.; Snabe, T.; Meyer, R.L. Antibacterial isoeugenol coating on stainless steel and polyethylene surfaces prevents biofilm growth. J Appl Microbiol 2018, 124, 179–187. [Google Scholar] [CrossRef] [PubMed]
- Cunliffe, A.J.; Askew, P.D.; Stephan, I.; Iredale, G.; Cosemans, P.; Simmons, L.M.; Verran, J.; Redfern, J. How do we determine the efficacy of an antibacterial surface? A review of standardised antibacterial material testing methods. Antibiotics 2021, 10, 1069. [Google Scholar] [CrossRef] [PubMed]
- Tobias, R. Antibacterial properties of dental restorative materials: a review. International endodontic journal 1988, 21, 155–160. [Google Scholar] [CrossRef] [PubMed]
- Olmos, D.; González-Benito, J. Polymeric materials with antibacterial activity: A review. Polymers 2021, 13, 613. [Google Scholar] [CrossRef] [PubMed]
- Ahmad, H. Celluloses as support materials for antibacterial agents: a review. Cellulose 2021, 28, 2715–2761. [Google Scholar] [CrossRef]
- Karwowska, E. Antibacterial potential of nanocomposite-based materials–a short review. Nanotechnology Reviews 2017, 6, 243–254. [Google Scholar] [CrossRef]
- Makvandi, P.; Jamaledin, R.; Jabbari, M.; Nikfarjam, N.; Borzacchiello, A. Antibacterial quaternary ammonium compounds in dental materials: A systematic review. Dental Materials 2018, 34, 851–867. [Google Scholar] [CrossRef] [PubMed]
- Loh, X.J. Latest advances in antibacterial materials. Journal of Molecular and Engineering Materials 2017, 5, 1740001. [Google Scholar] [CrossRef]
- Ferrando-Magraner, E.; Bellot-Arcís, C.; Paredes-Gallardo, V.; Almerich-Silla, J.M.; García-Sanz, V.; Fernández-Alonso, M.; Montiel-Company, J.M. Antibacterial properties of nanoparticles in dental restorative materials. A systematic review and meta-analysis. Medicina 2020, 56, 55. [Google Scholar] [CrossRef] [PubMed]
- Lei, C.; Yang, J.; Hu, J.; Sun, X. On the calculation of TCID50 for quantitation of virus infectivity. Virologica Sinica 2021, 36, 141–144. [Google Scholar] [CrossRef] [PubMed]
- LaBarre, D.D.; Lowy, R.J. Improvements in methods for calculating virus titer estimates from TCID50 and plaque assays. Journal of virological methods 2001, 96, 107–126. [Google Scholar] [CrossRef] [PubMed]
- Malenovska, H. Virus quantitation by transmission electron microscopy, TCID50, and the role of timing virus harvesting: A case study of three animal viruses. Journal of virological methods 2013, 191, 136–140. [Google Scholar] [CrossRef] [PubMed]
- Sachs, L.A.; Schnurr, D.; Yagi, S.; Lachowicz-Scroggins, M.E.; Widdicombe, J.H. Quantitative real-time PCR for rhinovirus, and its use in determining the relationship between TCID50 and the number of viral particles. Journal of virological methods 2011, 171, 212–218. [Google Scholar] [CrossRef] [PubMed]
- Lin, H.-T.; Tsai, H.-Y.; Liu, C.-P.; Yuan, T.T.-T. Comparability of bovine virus titers obtained by TCID50/ml and FAID50/ml. Journal of virological methods 2010, 165, 121–124. [Google Scholar] [CrossRef] [PubMed]
- Tyrrell, D.; Parsons, R. Some virus isolations from common colds. III. Cytopathic effects in tissue cultures. Lancet 1960, 239–242. [Google Scholar]
- Cotarelo, M.; Catalán, P.; Sánchez-Carrillo, C.; Menasalvas, A.; Cercenado, E.; Tenorio, A.; Bouza, E. Cytopathic effect inhibition assay for determining the in-vitro susceptibility of herpes simplex virus to antiviral agents. Journal of Antimicrobial Chemotherapy 1999, 44, 705–708. [Google Scholar] [CrossRef] [PubMed]
- Hu, Y.; Ma, C.; Wang, J. Cytopathic effect assay and plaque assay to evaluate in vitro activity of antiviral compounds against human coronaviruses 229E, OC43, and NL63. Bio-protocol 2022, 12, e4314–e4314. [Google Scholar] [CrossRef] [PubMed]
- Mehrbod, P.; Motamed, N.; Tabatabaeian, M.; SOLEYMANI, E.R.; Amini, E.; Shahidi, M.; Kheyri, M. In Vitro Antiviral Effect Of “Nanosilver” on Influenza Virus. DARU 2009, 17, 88–93. [Google Scholar]
- Wang, Y.-Z.; Cui, X.-L.; Gao, Y.-J.; Guo, S.-S.; Wang, X.-K.; Huang, Y.; Zhao, Y.; Gong, W.-F. Antivirus effects of extract from gardenia. Zhongguo Zhong yao za zhi= Zhongguo zhongyao zazhi= China journal of Chinese materia medica 2006, 31, 1176–1178. [Google Scholar] [PubMed]
- Nelson, D.L.; Cox, M.M. Lehninger Principles of Biochemistry, 6th Edition ed.; W.H.Freeman and Company: New York, the USA, 2013. [Google Scholar]
- Lee, G.; Bishop, P. Microbiology - and infection control for health professional, 6th Edition ed.; 2015.
- Lostroh, P. Molecular and cellular biology of viruses; Garland Science: 2019.
- Wulff, N.H.; Tzatzaris, M.; Young, P.J. Monte carlo simulation of the spearman-kaerber TCID50. Journal of clinical bioinformatics 2012, 2, 1–5. [Google Scholar] [CrossRef] [PubMed]
- Wilrich, C.; Wilrich, P.-T. Estimation of the POD function and the LOD of a qualitative microbiological measurement method. Journal of AOAC International 2009, 92, 1763–1772. [Google Scholar] [CrossRef] [PubMed]
- Darling, A.J.; Boose, J.A.; Spaltro, J. Virus assay methods: accuracy and validation. Biologicals 1998, 26, 105–110. [Google Scholar] [CrossRef] [PubMed]
- Characklis, W.G. Fouling biofilm development: a process analysis. Biotechnology and bioengineering 1981, 23, 1923–1960. [Google Scholar] [CrossRef]
- Characklis, W.G.; Cooksey, K.E. Biofilms and microbial fouling. In Advances in applied microbiology; Elsevier: 1983; Volume 29, pp. 93-138.
- J.W.Costerton; K.J.Cheng; Geesey, G.G.; I.Timothy; J.Ladd; Nckel, C.; Dasgupta, M.; Marrie, T.J. Bacterial biofilms in nature and disease. Annual reviews in Microbiology 1987, 41, 435-464.
- Lappin-Scott, H.M.; Costerton, J.W. Bacterial biofilms and surface fouling. Biofouling 1989, 1, 323–342. [Google Scholar] [CrossRef]
- Flemming, H.-C. Biofilme, Biofouling und mikrobielle Schädigung von Werkstoffen; Oldenbourg, München, Germany: München, 1994; pp.xvi, 277.
- Costerton, J.W.; Lewandowski, Z. The biofilm lifestyle. Advances in Dental Research 1997, 11, 192–195. [Google Scholar] [CrossRef]
- Flemming, H.-C.; Szewzyk, U.; Griebe, T. Biofilms - Investigative Methods & Applications; CRC Press: Boca Raton, FL, the USA, 2000. [Google Scholar]
- Lewandowski, Z.; Beyenal, H. Fundamentals of Biofilm Research, Second Edition ed.; CRC Press: Boca Raton, London, New York, 2014. [Google Scholar]
- Merritt, J.H.; Kadouri, D.E.; O’Toole, G.A. Growing and analyzing static biofilms. Current protocols in microbiology 2011, 22, 1B. 1.1–1B 118. [Google Scholar] [CrossRef]
- Abbanat, D.; Shang, W.; Amsler, K.; Santoro, C.; Baum, E.; Crespo-Carbone, S.; Lynch, A.S. Evaluation of the in vitro activities of ceftobiprole and comparators in staphylococcal colony or microtitre plate biofilm assays. International journal of antimicrobial agents 2014, 43, 32–39. [Google Scholar] [CrossRef] [PubMed]
- Eigentler, L.; Davidson, F.A.; Stanley-Wall, N.R. Mechanisms driving spatial distribution of residents in colony biofilms: an interdisciplinary perspective. Open Biology 2022, 12, 220194. [Google Scholar] [CrossRef] [PubMed]
- Stepanović, S.; Vuković, D.; Hola, V.; Bonaventura, G.D.; Djukić, S.; Ćirković, I.; Ruzicka, F. Quantification of biofilm in microtiter plates: overview of testing conditions and practical recommendations for assessment of biofilm production by staphylococci. Apmis 2007, 115, 891–899. [Google Scholar] [CrossRef] [PubMed]
- O’Toole, G.A.Microtiter dish biofilm formation assay. JoVE (Journal of Visualized Experiments) 2011, e2437.
- Djordjevic, D.; Wiedmann, M.; McLandsborough, L. Microtiter plate assay for assessment of Listeria monocytogenes biofilm formation. Applied and environmental microbiology 2002, 68, 2950–2958. [Google Scholar] [CrossRef] [PubMed]
- Haney, E.F.; Trimble, M.J.; Hancock, R.E. Microtiter plate assays to assess antibiofilm activity against bacteria. Nature protocols 2021, 16, 2615–2632. [Google Scholar] [CrossRef]
- Elkhatib, W.F.; Khairalla, A.S.; Ashour, H.M. Evaluation of different microtiter plate-based methods for the quantitative assessment of Staphylococcus aureus biofilms. Future Microbiology 2014, 9, 725–735. [Google Scholar] [CrossRef] [PubMed]
- Boltz, J.P.; Smets, B.F.; Rittmann, B.E.; Van Loosdrecht, M.C.; Morgenroth, E.; Daigger, G.T. From biofilm ecology to reactors: a focused review. Water Science and Technology 2017, 75, 1753–1760. [Google Scholar] [CrossRef] [PubMed]
- Germec, M.; Demirci, A.; Turhan, I. Biofilm reactors for value-added products production: an in-depth review. Biocatalysis and agricultural biotechnology 2020, 27, 101662. [Google Scholar] [CrossRef]
- Saravanan, V.; Sreekrishnan, T. Modelling anaerobic biofilm reactors—A review. Journal of environmental management 2006, 81, 1–18. [Google Scholar] [CrossRef] [PubMed]
- Ercan, D.; Demirci, A. Current and future trends for biofilm reactors for fermentation processes. Critical reviews in biotechnology 2015, 35, 1–14. [Google Scholar] [CrossRef] [PubMed]
- Shahot, K.; Idris, A.; Omar, R.; Yusoff, H.M. Review on biofilm processes for wastewater treatment. Life Sci J 2014, 11, 1–13. [Google Scholar]
- Gjaltema, A.; Arts, P.; Van Loosdrecht, M.; Kuenen, J.G.; Heijnen, J. Heterogeneity of biofilms in rotating annular reactors: occurrence, structure, and consequences. Biotechnology and bioengineering 1994, 44, 194–204. [Google Scholar] [CrossRef] [PubMed]
- Hoh, D.; Watson, S.; Kan, E. Algal biofilm reactors for integrated wastewater treatment and biofuel production: a review. Chemical Engineering Journal 2016, 287, 466–473. [Google Scholar] [CrossRef]
- di Biase, A.; Kowalski, M.S.; Devlin, T.R.; Oleszkiewicz, J.A. Moving bed biofilm reactor technology in municipal wastewater treatment: a review. Journal of environmental management 2019, 247, 849–866. [Google Scholar] [CrossRef] [PubMed]
- Kuehn, M.; Hausner, M.; Bungartz, H.-J.; Wagner, M.; Wilderer, P.A.; Wuertz, S. Automated confocal laser scanning microscopy and semiautomated image processing for analysis of biofilms. Applied and environmental microbiology 1998, 64, 4115–4127. [Google Scholar] [CrossRef] [PubMed]
- Lawrence¹, J.R.; Wolfaardt, G.M.; Neu, T.R. The study of biofilms using confocal laser scanning microscopy. Digital Image Analysis of Microbes: Imaging, Morphometry, Fluorometry and Motility Techniques and Applications 1998, 431.
- Neu, T.R.; Lawrence, J.R. Investigation of microbial biofilm structure by laser scanning microscopy. Productive Biofilms 2014, 1–51. [Google Scholar]
- Schlafer, S.; Meyer, R.L. Confocal microscopy imaging of the biofilm matrix. Journal of Microbiological methods 2017, 138, 50–59. [Google Scholar] [CrossRef] [PubMed]
- Reichhardt, C.; Parsek, M.R. Confocal laser scanning microscopy for analysis of Pseudomonas aeruginosa biofilm architecture and matrix localization. Frontiers in microbiology 2019, 10, 677. [Google Scholar] [CrossRef] [PubMed]
- Little, B., Wagner, P., Ray, R., Pope, R., & Scheetz, R.(1991). Biofilms: an ESEM evaluation of artifacts introduced during SEM preparation. Journal of industrial microbiology, 8(4), 213–221.
- Araujo, J. C., Téran, F. C., Oliveira, R. A., Nour, E. A., Montenegro, M. A., Campos, J. R., & Vazoller, R. F. (2003). Comparison of hexamethyldisilazane and critical point drying treatments for SEM analysis of anaerobic biofilms and granular sludge. Journal of electron microscopy, 52(4), 429–433.
- Schaudinn, C., Carr, G., Gorur, A., Jaramillo, D.,Costerton, J. W., & Webster, P. (2009). Imaging of endodontic biofilms by combined microscopy (FISH/cLSM SEM). Journal of microscopy, 235(2), 124–127.
- Hoa, M., Tomovic, S., Nistico, L., Hall-Stoodley, L.,Stoodley, P., Sachdeva, L., … & Coticchia, J. M. (2009). Identification of adenoid biofilms with middle ear pathogens in otitis-prone children utilizing SEM and FISH. International journal of pediatric otorhinolaryngology, 73(9), 1242–1248.
- Reese, S., & Guggenheim, B. (2007). A novel TEM contrasting technique for extracellular polysaccharides in in vitro biofilms. Microscopy research and technique, 70(9), 816–822.
- Amorena, B., Gracia, E., Monzón, M., Leiva, J., Oteiza, C., Pérez, M.,…& Hernández-Yago, J. (1999). Antibiotic susceptibility assay for Staphylococcus aureus in biofilms developed in vitro. Journal of Antimicrobial Chemotherapy, 44 (1), 43–55.
- Surman, S. B., Walker, J. T., Goddard, D. T., Morton, L. H. G., Keevil, C. W., Weaver, W.,…& Kurtz, J. (1996). Comparison of microscope techniques for the examination of biofilms. Journal of Microbiological Methods, 25(1), 57–70.
- Sanclement, J. A., Webster, P., Thomas, J., & Ramadan, H. H. (2005). Bacterial biofilms in surgical specimens of patients with chronic rhinosinusitis. The Laryngoscope, 115(4), 578–582.
- Buret, A., Ward, K. H., Olson, M. E., & Costerton, J. W. (1991). An in vivo model to study the pathobiology of infectious biofilms on biomaterial surfaces. Journal of biomedical materials research, 25(7), 865–874.
- Beech, I. B., Cheung, C. S., Johnson, D. B., & Smith, J. R. (1996). Comparative studies of bacterial biofilms on steel surfaces using atomic force microscopy and environmental scanning electron microscopy.Biofouling, 10(1-3), 65–77.
- Fang, H. H., Chan, K.-Y., & Xu, L.-C. (2000). Quantification of bacterial adhesion forces using atomic force microscopy (AFM). Journal of microbiological methods, 40(1), 89–97.
- Auerbach, I. D., Sorensen, C., Hansma, H. G., & Holden, P. A. (2000). Physical morphology and surface properties of unsaturated Pseudomonas putida biofilms. Journal of bacteriology, 182(13), 3809–3815.
- Beech, I. B., Smith, J. R., Steele, A. A., Penegar, I., & Campbell, S. A. (2002). The use of atomic force microscopy for studying interactions of bacterial biofilms with surfaces. Colloids and Surfaces B: Biointerfaces, 23(2-3), 231–247.
- Yuan, S. J., & Pehkonen, S. O. (2007). Microbiologically influenced corrosion of 304 stainless steel by aerobic Pseudomonas NCIMB 2021 bacteria: AFM and XPS study. Colloids Surf B Biointerfaces, 59(1), 87–99. [CrossRef]
- Wright, C. J., Shah, M. K., Powell, L. C., & Armstrong, I. (2010). Application of AFM from microbial cell to biofilm. Scanning, 32(3), 134–149.
- Díaz, C., Schilardi, P., Salvarezza, R., & de Mele, M. F. L. (2011). Have flagella a preferred orientation during early stages of biofilm formation?: AFM study using patterned substrates. Colloids and Surfaces B: Biointerfaces, 82(2), 536–542.
- Harimawan, A., Zhong, S., Lim, C. T., & Ting, Y. P. (2013). Adhesion of B. subtilis spores and vegetative cells onto stainless steel--DLVO theories and AFM spectroscopy. J Colloid Interface Sci, 405, 233–241. [CrossRef]
- Beech, I. B. (1996). The potential use of atomic force microscopy for studying corrosion of metals in the presence of bacterial biofilms—an overview. International biodeterioration & biodegradation, 37 (3-4), 141–149.
- Beech, I. B., Cheung, C. S., Johnson, D. B., & Smith, J.R. (1996). Comparative studies of bacterial biofilms on steel surfaces using atomic force microscopy and environmental scanning electron microscopy.Biofouling, 10(1-3), 65–77.
- Arnold, J.,&Bailey, G. (2000). Surfacefinishes on stainless steel reduce bacterial attachment and early biofilm formation: scanning electron and atomic force microscopy study. Poultry science, 79(12), 1839–1845.
- Neu, T. R., & Lawrence, J. R. (1999). In situ characterization of extracellular polymeric substances (EPS) in biofilm systems. In Microbial Extracellular Polymeric Substances (pp. 21–47): Springer.
- Beech, I. B., Tapper, R. C., & Gubner, R. J. (2000). Microscopy methods for studying biofilms. Biofilms: Recent advances in their study and control, 51–70.
- Malvankar, N. S., Tuominen, M. T., & Lovley, D. R. (2012). Lack of cytochrome involvement in longrange electron transport through conductive biofilms and nanowires of Geobacter sulfurreducens. Energy & Environmental Science, 5(9), 8651–8659.
- Neu, T. R., Manz, B., Volke, F., Dynes, J. J., Hitchcock, A. P., & Lawrence, J. R. (2010). Advanced imaging techniques for assessment of structure, composition and function in biofilm systems. FEMS microbiology ecology, 72(1), 1–21.
- Schechter, M., Schechter, A., Rozenfeld, S., Efrat, E., & Cahan, R. (2014). Anode biofilm. In Technology and Application of Microbial Fuel Cells: IntechOpen.
- Millo, D., Harnisch, F., Patil, S. A., Ly, H. K., Schröder, U., & Hildebrandt, P. (2011). In situ spectroelectrochemical investigation of electrocatalytic microbial biofilms by surface-enhanced resonance Raman spectroscopy. Angewandte Chemie International Edition, 50(11), 2625–2627.
- Schmid, T., Messmer, A., Yeo, B. S., Zhang, W., & Zenobi, R. (2008). Towards chemical analysis of nanostructures in biofilms II: tip-enhanced Raman spectroscopy of alginates. Analytical and bioanalytical chemistry, 391(5), 1907–1916.
- Virdis, B., Harnisch, F., Batstone, D. J., Rabaey, K., & Donose, B. C. (2012). Non-invasive characterization of electrochemically active microbial biofilms using confocal Raman microscopy. Energy & Environmental Science, 5(5), 7017–7024.
- Sandt, C., Smith-Palmer, T., Pink, J., Brennan, L., & Pink, D. (2007). Confocal Raman microspectroscopy as a tool for studying the chemical heterogeneities of biofilms in situ. Journal of applied microbiology, 103 (5), 1808–1820.
- Schmitt, J., & Flemming, H. C. (1998). FTIR-spectroscopy in microbial and material analysis. International Biodeterioration & Biodegradation, 41 (1), 1–11.
- Schmitt, J., Nivens, D., White, D. C., & Flemming, H. C. (1995). Changes of biofilm properties in response to sorbed substances-an FTIR-ATR study. Water Science and Technology, 32(8), 149–155.
- Holman, H. Y. N., Miles, R., Hao, Z., Wozei, E., Anderson, L. M., & Yang, H. (2009). Real-time chemical imaging of bacterial activity in biofilms using open channel microfluidics and synchrotron FTIR spectromicroscopy. Analytical chemistry, 81 (20), 8564–8570.
- Quilès, F., Humbert, F., & Delille, A. (2010). Analysis of changes in attenuated total reflection FTIR fingerprints of Pseudomonas fluorescens from planktonic state to nascent biofilm state. Spectrochimica Acta Part A: Molecular and Biomolecular Spectroscopy, 75(2), 610–616.
|
Disclaimer/Publisher’s Note: The statements, opinions and data contained in all publications are solely those of the individual author(s) and contributor(s) and not of MDPI and/or the editor(s). MDPI and/or the editor(s) disclaim responsibility for any injury to people or property resulting from any ideas, methods, instructions or products referred to in the content. |
© 2024 by the authors. Licensee MDPI, Basel, Switzerland. This article is an open access article distributed under the terms and conditions of the Creative Commons Attribution (CC BY) license (http://creativecommons.org/licenses/by/4.0/).